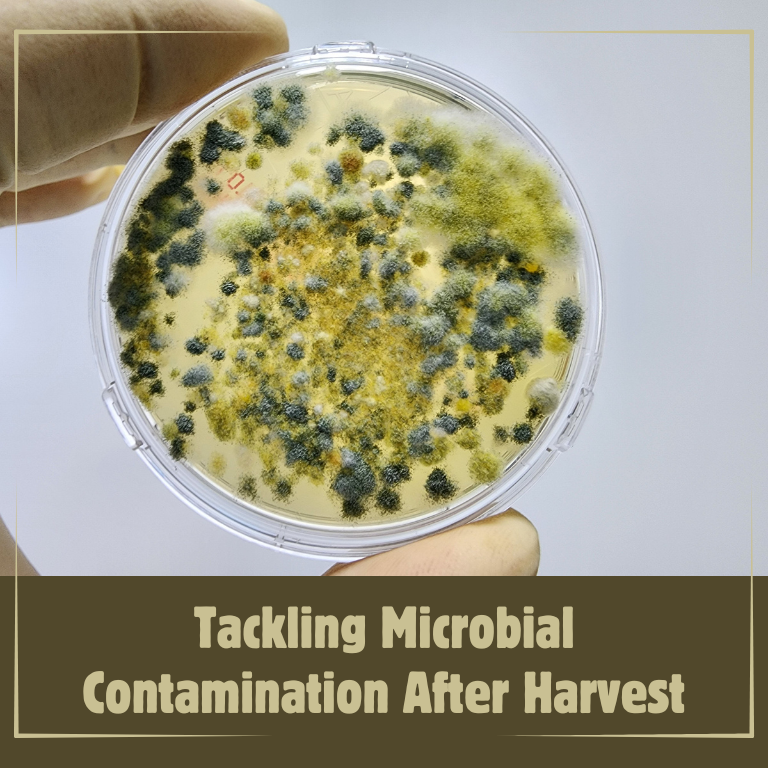
Tackling Microbial Contamination After Harvest

Cannabis Industry News You Can Use
Cannabis Proven Free of Genotoxic Effects in Study
Wellness Takes Center Stage for Cannabis Workers in 2025
Minnesota’s Cannabis Market in 2024: Trends and 2025 Insights
California’s Best-Selling Flower Strains of 2024
Latest News

New York’s Cannabis Sales Projected to Hit $520M in 2024
New York’s Adult-Use Cannabis Market Shows Significant Growth in 2024 New York’s adult-use cannabis market is experiencing a robust resurgence…

Committee Pushes VA to Explore Cannabis as Opioid Alternative
Senate Committee Urges VA to Explore Medical Marijuana as Opioid Alternative for Veterans In a significant move, a Senate committee…

Snoop Dogg Opens First Dispensary, Honors 2Pac with New Line
Snoop Dogg Expands Cannabis Legacy with New Dispensary and 2Pac Tribute Products Snoop Dogg, a name synonymous with marijuana culture,…

Curaleaf Joins MSOs in Hemp-Derived THC Market Shift
Curaleaf Holdings Reverses Hemp Exit, Embraces Market with New Product Line Curaleaf Holdings, a prominent New York-based marijuana multistate operator,…
Tackling Microbial Contamination After Harvest
Introduction to Microbial Contamination After Harvest Microbial contamination after harvest is a significant concern for producers and consumers alike. Addressing…

Regulatory Delays Stall Ohio Recreational Cannabis Sales
Ohio Dispensaries Prepare for Recreational Cannabis Sales Over 100 Ohio medical cannabis dispensaries are on their way to selling recreational…

Managing Cannabis Pests: The Impact of Poor Environmental Control
Introduction to Cannabis Pest Management Managing pests in cannabis cultivation is crucial for ensuring healthy, high-yielding plants. Effective pest management…

Exploring Ricky Williams’ New Business Ventures in Cannabis
Ricky Williams: The Heisman Winner and NFL Legend Credits Cannabis for Helping His NFL Career, New Business Venture Ricky Williams,…

Enhancing Cannabis Cultivation with Proper Air Quality
Introduction to Air Quality in Cannabis Cultivation Proper air quality is a critical factor in cannabis cultivation that significantly impacts…
Risk Management

Wellness Takes Center Stage for Cannabis Workers in 2025
The cannabis industry has experienced unprecedented growth over the last decade, creating a wide array of opportunities for workers in…

Risk Mitigation Strategies for Cannabis Equipment Providers
As the cannabis industry continues to expand, cannabis equipment providers face a unique set of challenges that require careful attention…

First Year in Cannabis Retail: High Injury Risk for Workers
The cannabis industry has experienced significant growth over the past decade, with new markets opening up as more states legalize…

Improved Safety: Fewer Job Deaths in Cannabis in 2023
Improved Safety in the Cannabis Industry: Fewer Job Deaths in 2023 Highlight Progress and Challenges The cannabis industry, a rapidly…

Skilled Worker Shortage Challenges Fire Protection in 2025
Skilled Worker Shortage Challenges Fire Protection in 2025: Implications for the Cannabis Industry The cannabis industry, one of the fastest-growing…

Cannabis Industry Adapts to ASSP’s New Safety Training Guidelines
Cannabis Industry Adapts to ASSP’s New Safety Training Guidelines: A Comprehensive Approach to Workplace Safety in the Cannabis Sector The…

Tech Meets Emergency Management to Boost Cannabis Fire Safety
The rapid growth of the cannabis industry has introduced a range of challenges, including fire safety risks that must be…

2023 OSHA Data Reveals Injuries and Illnesses in Cannabis Sector
The cannabis industry has been growing rapidly in recent years, with legalization spreading across various states in the U.S. As…

OSHA Finalizes PPE Regulations for the Construction Industry
Improperly-Sized PPE and Its Impact on Construction Worker Safety: An OSHA Revision to Address a Longstanding Industry Concern In the…











